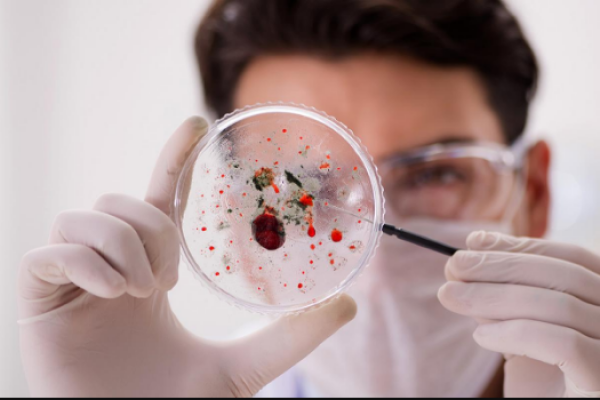

Diplomado en Patología Forense para Enfermería
Diplomado
Online

¡Una gran oportunidad para formarte!
-
Tipología
Diplomado
-
Metodología
Online
-
Horas lectivas
200h
-
Duración
2 Meses
-
Inicio
Fechas disponibles
-
Campus online
Sí
-
Clases virtuales
Sí
La especialidad de enfermería legal y forense es la gran demandada a nivel internacional. Hasta la fecha, desconocida en nuestro país debido al exceso de confianza en profesionales afines para determinar la causalidad y culpabilidad de ciertos sucesos y sujetos a la hora de ser enjuiciados.
Muchos son los médicos, enfermeros y especialistas que desean formarse en este ámbito para poder ampliar o comenzar su capacitación en la rama de la ciencia forense.
Información importante
Documentos
- 242diplomado-patologia-forense-enfermeria--.pdf
Sedes y fechas disponibles
Ubicación
inicio
inicio
Información relevante sobre el curso
Objetivos Generales
Actualizar los conocimientos del profesional con especial formación e interés en el campo de la Enfermería legal y forense
Promover estrategias de trabajo basadas en el abordaje integral del peritado como modelo de referencia en la consecución de la excelencia pericial
Favorecer la adquisición de habilidades y destrezas técnicas, mediante un sistema audiovisual potente, y posibilidad de desarrollo a través de talleres online de simulación y/o formación específica.
Objetivo Específico
Realizar un estudio profundo sobre las fases y fenómenos cadavéricos
El Diplomado en Patología Forense para Enfermería está orientado a facilitar la actuación del médico ante todo tipo de pacientes en riesgo toxicológico grave o con intoxicación aguda
Este Diplomado en Patología Forense para Enfermería contiene el programa científico más completo y actualizado del mercado.
Tras la superación de las evaluaciones por parte del alumno, éste recibirá por correo postal con acuse de recibo su correspondiente Título de Curso Universitario emitido por la TECH - Universidad Tecnológica.
El título expedido por la TECH - Universidad Tecnológica expresará la calificación que haya obtenido en el Curso, y reúne los requisitos comúnmente exigidos por las bolsas de trabajo, oposiciones y comités evaluadores carreras profesionales.
Título: Diplomado en Patología Forense para Enfermería
Nº Horas Oficiales: 200
Nuestra escuela es la primera en el mundo que combina el estudio de casos clínicos con un sistema de aprendizaje 100% online basado en la reiteración, que combina 8 elementos diferentes que suponen una evolución con respecto al simple estudio y análisis de casos. Esta metodología, a la vanguardia pedagógica mundial, se denomina Relearning.
Nuestra escuela es la primera en habla hispana licenciada para emplear este exitoso método, habiendo conseguido en 2015 mejorar los niveles de satisfacción global (calidad docente, calidad de los materiales, estructura del curso, objetivos…) de los estudiantes que finalizan los cursos con respecto a los indicadores de la mejor universidad online en habla hispana.
Recibida su solicitud, un responsable académico del curso le llamará para explicarle todos los detalles del programa, así como el método de inscripción, facilidades de pago y plazos de matrícula.
En primer lugar, necesitas un ordenador (PC o Macintosh), conexión a internet y una cuenta de correo electrónico. Para poder realizar los cursos integramente ON-LINE dispone de las siguientes opciones: Flash - Instalando Flash Player 10 o posterior (http://www.adobe.com/go/getflash), en alguno de los siguientes navegadores web: - Windows: Internet Explorer 6 y posteriores, Firefox 1.x y posteriores, Google Chrome, Opera 9.5 y posteriores - Mac: Safari 3 y posteriores, Firefox 1.x y posteriores, Google Chrome - Linux: Firefox 1.x y posteriores HTML5 - Instalando alguno de los navegadores web: - Google Chrome 14 o posterior sobre Windows o Mac - Safari 5.1 o posterior sobre Mac - Mobile Safari sobre Apple iOS 5.0 o posterior en iPad/iPhone Apple iOS - Articulate Mobile Player; Apple iOS 5.0 o posterior en iPad.
Opiniones
Logros de este Centro
Todos los cursos están actualizados
La valoración media es superior a 3,7
Más de 50 opiniones en los últimos 12 meses
Hace 8 años que este centro está en Emagister.
Materias
- Enfermería
- Forense
- Patología forense
- Muerte
- Lesiones
Profesores
Carlos Cuadrado Gómez-Serranillos
Doctor en Medicina (MD) y Cirugía por la Universidad de California FCE
Plan de estudios
Módulo 1. Patología forense I
1.1. Mecanismos de muerte en las lesiones
1.1.1. Clasificación
1.1.2. Destrucción de Centros Vitales
1.1.3. Hemorragias
1.2. Diagnóstico de la muerte por shock traumático y embolias
1.2.1. Concepto
1.2.2. Mecanismo de producción
1.3. Síndrome de disfunción multiorgánica
1.3.1. Definición y concepto
1.4. Mecanismos de la muerte de origen natural
1.4.1. Concepto y clasificación
1.5. Muerte natural de origen cardiovascular y respiratorio
1.5.1. Concepto y clasificación
1.6. Muerte natural de origen neurológico
1.6.1. Concepto y diagnóstico
1.7. Muerte natural de origen digestivo y metabólico
1.8. Muerte súbita en la infancia
1.8.1. Clasificación
1.8.2. Posibles Muertes camufladas (malos tratos)
1.9. Muerte súbita del adulto
1.9.1. Concepto y clasificación
1.10. Estudio de las contusiones
1.10.1. Signos de lucha
1.10.2. Signos de defensa
1.11. Heridas por arma blanca
1.11.1. Tipos de herida
1.11.2. Mecanismo de producción
1.12. Heridas por arma de fuego
1.12.1. Tipos de herida
1.12.1.1. Heridas de entrada
1.12.1.2. Heridas de salida
1.12.1.3. Mecanismo de producción
1.13. Lesiones por electricidad
1.13.1. Concepto
1.13.2. Mecanismo de producción
1.14. Lesiones de frío, radiaciones y presión atmosférica
1.14.1. Concepto
1.14.2. Clasificación
1.14.3. Mecanismo de producción
1.15. Lesiones por calor y quemaduras
1.15.1. Concepto
1.15.2. Clasificación
1.15.3. Identificación
1.16. Lesiones en incendios
1.16.1. Concepto
1.16.2. Clasificación
1.16.3. Identificación
1.17. Lesiones por explosiones
1.18. Grandes catástrofes
Diplomado en Patología Forense para Enfermería